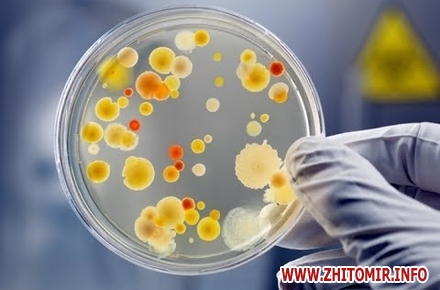

Епідемічна ситуація з гострих кишкових інфекційних захворювань та харчових отруєнь в Житомирській області впродовж І півріччя 2018 року характеризується, як стабільна.
Про це 9 липня інформує головне управління Держпродспоживслужби у Житомирській області.
«З початку 2018 року в області зареєстровано спалах вірусного гепатиту «А», внаслідок якого постраждало 5 дітей до 17 років. За аналогічний період минулого року було зареєстровано 2 спалахи, де перехворіло 32 особи, всі діти до 17 років. Спалах виник серед учнів загальноосвітньої школи І-ІІІ ступеню с.Холосне Коростенського району. Головними причинами спалаху стали: порушення протиепідемічного, санітарно-гігієнічного та питного режимів в закладі, не дотримання правил особистої гігієни учнями. Протиепідемічні заходи у вогнищі завершені», – йдеться у повідомленні.
«Окрім того, з початку 2018 року в області зареєстровано 3 побутових випадки ботулізму, в наслідок яких постраждало 3 дорослих осіб (с.Великий Молодьків Новоград-Волинського району, с.Йосипівка Малинського району та с. Березники Ємільчинського району). Випадок в Ємільчинському районі закінчився летально. Причинами отруєння стали продукти домашнього виготовлення: домашня тушонка та консервовані гриби. В І півріччі 2017 року було зареєстровано 2 випадки захворювання на ботулізм з 2 потерпілими. Зареєстровано один випадок отруєння грибами в побуті з однією потерпілою (с. Мала Деревичка Любарського району) як і за аналогічний період минулого року. Спеціалісти територіальних органів Держпродспоживслужби взяли участь у проведенні санітарно-епідеміологічних розслідувань випадків харчових отруєнь», - зазначили у Держпродспоживслужбі.
Як повідомляв Житомир.info, у Житомирській області щорічно на збудники паразитарних хвороб обстежується до 500 тис. осіб. У 2017 р. було обстежено 433573 осіб, що становить 35% від числа проживаючих в області.